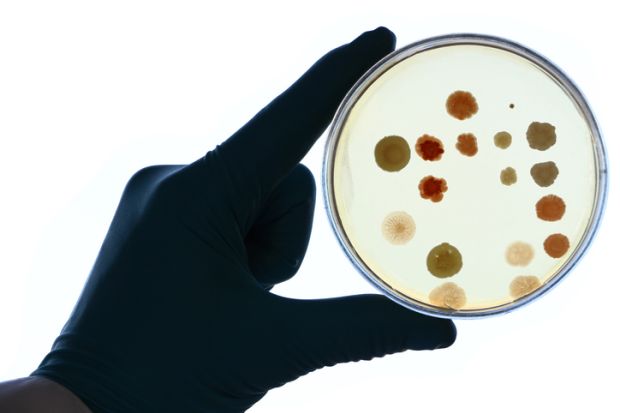

Peer review is not enough to protect people from potentially lethal misinformation in an age of coronavirus, an Australian forum has heard.
University of Sydney chemist Toby Hudson said the potentially fatal consequences of scientific misrepresentation during the pandemic had underlined the need for “more radical transparency” than the peer review process normally allowed.
Dr Hudson told an Open Access Australasia webinar that habitual fact-checking had been “falling over” during the pandemic. “We need to be linking back to our sources, but those sources need to be available for proper critique.
“[They need] to be open – to write, to read, to audit, to critique and to change or update. We need a big commitment to…making sure we can get all the way back up the ladder to reliable sources that have been peer reviewed.”
Dr Hudson, associate head of education in the university’s chemistry school, is also a fervent “Wikipedian” who writes content for the online encyclopaedia and its machine-readable cousin Wikidata. He said readers had been confused and sometimes misled by the reporting of “fair-minded” journalists. “Because the study the journalist was quoting…was inaccessible to the public, they couldn’t properly interrogate it.”
The webinar was the first of a series marking International Open Access Week from 25 October. Andrew Jaspan, founder of The Conversation website, said the pandemic and the storming of the US Capitol had forced people to “rethink the whole content supply chain”.
Professor Jaspan likened information to water supply. “When you switch your tap on, you assume that tests have been carried out downstream so that it’s potable, reliable and safe. The same thing goes for information. Bad, polluted information can cost lives or be extremely damaging.”
Prue Torrance, executive director of research quality with Australia’s National Health and Medical Research Council, said that while peer review was “absolutely critical” it was “also not infallible”.
She said science must be “constantly open to criticism or questioning”. This required access to research and its underlying data, which occasionally led to corrections and retractions. “Those checks and balances don’t pick up [a huge number of] problems,” she said. “What’s really important is that those checks and balances are there.”
Australia’s chief scientist, Cathy Foley, cited a recent example where interrogation of original data had led to the withdrawal of a paper in the journal Nature. The authors had been “horrified” to realise that they had not analysed their data correctly, she said.
“This wasn’t anyone trying to do the wrong thing or diddle the books,” Dr Foley said. “It was just human error. That whole process highlighted the strength of open science.”
Ms Torrance said scientific disinformation during the pandemic had made people more critical about models of dissemination, including preprints – a mode embraced more by the media and policymakers than the academic community, she said.
While people needed to understand the limitations of research yet to undergo peer review, preprints helped boost research integrity by maintaining records of publication through unique digital identifiers.
“While versions will change over time, you’ll always be directed from any link to the most up to date version. Most preprint servers will let you see previous versions and what’s changed to get that sense, too. It’s a strong mechanism to improve the quality and the integrity of that particular piece of research over time.”
Register to continue
Why register?
- Registration is free and only takes a moment
- Once registered, you can read 3 articles a month
- Sign up for our newsletter
Subscribe
Or subscribe for unlimited access to:
- Unlimited access to news, views, insights & reviews
- Digital editions
- Digital access to THE’s university and college rankings analysis
Already registered or a current subscriber?